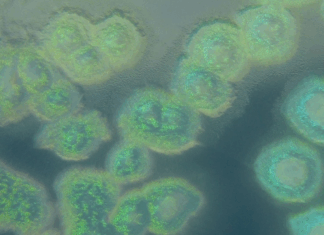

Últimas entradas
DESTACADOS
Plantean usar inteligencia artificial para potenciar agricultura en la Región del...
Cuarta versión de los seminarios internacionales del Programa Regional de CONICYT, realizada en Talca, reunió a expertos que debatieron en torno a la llamada...
VIDEOS
ULTIMAS PUBLICACIONES
Investigación del CEAF revela cómo el clima extremo afecta a los cultivos en Chile
Investigaciones del Centro de Estudios Avanzados en Fruticultura (CEAF) buscan comprender cómo la sequía, el calor extremo y la salinidad del suelo afectan a...
Convocan a estudiantes de todo Chile a participar en la Feria Antártica Escolar 2026...
El Instituto Antártico Chileno (INACH) abrió oficialmente la convocatoria para la 23.ª versión de la Feria Antártica Escolar (FAE 2026), una iniciativa nacional que...
La informática encuentra un aliado en los hongos
La computación fúngica explora una idea que hasta hace poco parecía ciencia ficción: utilizar redes de hongos como soporte para procesar información. Investigadores de...
Investigación revela mayor diversidad de algas rojas en el Pacífico suroriental y describe tres...
Un estudio liderado por un equipo internacional actualizó el conocimiento sobre las algas rojas del orden Bangiales en la costa del Perú, revelando una...
Chile será sede de encuentro latinoamericano para mapear los bosques de macroalgas del Pacífico
Investigadores de Iberoamérica se reunirán en abril en la Estación Costera de Investigaciones Marinas de Las Cruces para compartir avances científicos sobre el monitoreo...
REDES SOCIALES
MÁS VISTOS
Bacterias sobreviven 30 años en agua pesada: un hallazgo que redefine...
Investigadoras e investigadores del CSIC descubren comunidades bacterianas activas en un medio tóxico, abriendo nuevas posibilidades para la astrobiología y la biotecnología.
En un avance...